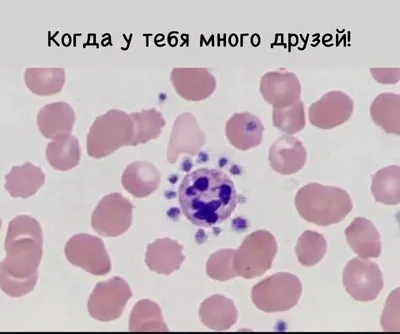

Клиническая лабораторная диагностика LabHub
МедицинаКоманда специалистов клинической лабораторной диагностики. Всё о медицинских анализах. Сайт: https://labhub.online
Мониторьте этот канал — посты, тренды, конкуренты
Обзор канала
- Платформа Telegram
- Категория Медицина
- Подписчики 8 210
- Температура Тёплый
- Постов/день 1.0
- Тип Публичный
Динамика подписчиков
Это ваш канал?
Подключите TeleGraphyx Traffic и получайте целевых подписчиков от 15₽. Интеграция с Яндекс.Директ, готовые лендинги, ежедневные отчёты.
Вовлечённость (ERR)
Анализ публикаций
30 днейТипы контента
Популярные посты
Автор: Екатерина Долгобородова 🙏 Нарисовала такой вот лабораторный комикс-памятку для медсестёр нашей больницы 😃

🔬Находки с WB🧪
Приглашаем вас на вебинар "Цифровизация морфологических исследований в лаборатории" 🗓 11 марта 2026 🕚 11:00 Цифровизация исследований значительно ускоряет процессы, повышая точность и расширя

Дорогие коллеги! 👋 Только что завершился Российский форум по тромбозу и гемостазу 2026 - и мы рады поделиться, что выступили там с устным докладом на тему, которая близка каждому, кто работает с гем

Уже через неделю, 19 и 20 марта, встречаемся на форуме «LabNext:Лаборатория: время перемен»! Мы делились секретами научной программы на сайте, в рассылках и социальных сетях. Как вспомнить важное? По
🎉Уважаемые коллеги, рады сообщить Вам, что Российский форум по тромбозу и гемостазу, который состоится 12-14 марта 2026 года, одобрена Комиссией по оценке учебных материалов для НМО. 1 день 2 день

Коллеги, добрый день! Есть ли у вас в лаборатории хемилюминометр для научных целей? Необходимо измерить продукцию активных форм кислорода полиморфно-ядерными лейкоцитами периферической крови донора ме

🚀 Хватит ждать у моря погоды. Действуйте! Коллеги, напоминаю, что 17 марта - финальный день подачи заявок на акселератор «Сириус». Это ваш шанс: 🔹 «Упаковать» свой проект в лабораторной диагностик

⏰
🥰
Похожие каналы
Подобраны AI по тематике и контенту
Обзор канала
- Платформа Telegram
- Категория Медицина
- Подписчики 8 210
- Температура Тёплый
- Постов/день 1.0
- Тип Публичный
Хотите контент как у лучших? AI сделает
AI изучит стиль топовых каналов в нише и создаст уникальные посты, обложки и стратегию для вашего канала. Полный автопилот — от идеи до публикации.
Подписывайтесь на наши каналы
Кейсы, лайфхаки и новости о продвижении в мессенджерах

